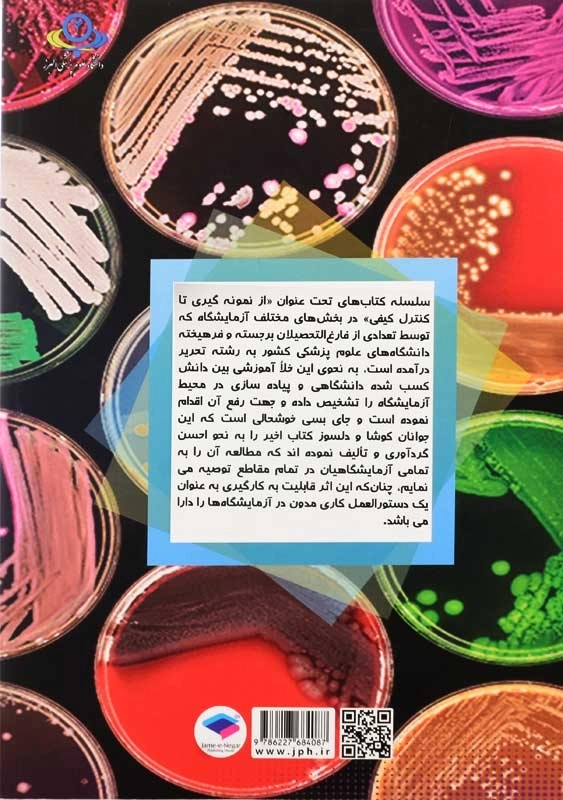
کتاب از نمونه گیری تا کنترل کیفی در آزمایشگاه باکتریولوژی - 1

دربارهی کتاب از نمونه گیری تا کنترل کیفی در آزمایشگاه باکتریولوژی
کتاب از نمونه گیری تا کنترل کیفی در آزمایشگاه باکتریولوژی نشر جامعه نگر، برای دانشجویان علوم پزشکی از جمله رشتههای میکروبیولوژی، علوم آزمایشگاهی و باکتریشناسی پزشکی مناسب است. به دو بخش تقسیم شده است: بخش اول در رابطه با پایههای تشخیصی و روشهای تشخیصی باکتریال بحث شده است. در بخش دوم به بررسی تشخیص آزمایشگاهی در نمونههای مختلف بالینی با استانداردهای بینالمللی پرداخته است.
کتاب از نمونه گیری تا کنترل کیفی در آزمایشگاه باکتریولوژی، با تالیف گروه نویسندگان، توسط انتشارات جامعه نگر به چاپ رسیده است.
- مولف: جمعی از نویسندگان
- انتشارات: جامعه نگر